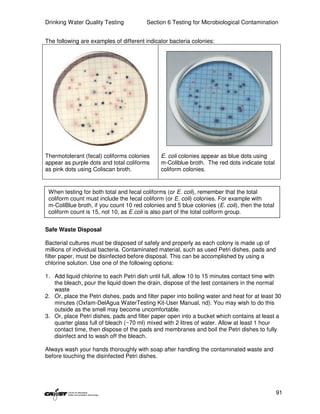
Drinking Water Quality Testing           Section 6 Testing for Microbiological Contamination


The following are examples of different indicator bacteria colonies:




Thermotolerant (fecal) coliforms colonies      E. coli colonies appear as blue dots using
appear as purple dots and total coliforms      m-Coliblue broth. The red dots indicate total
as pink dots using Coliscan broth.             coliform colonies.


 When testing for both total and fecal coliforms (or E. coli), remember that the total
 coliform count must include the fecal coliform (or E. coli) colonies. For example with
 m-ColiBlue broth, if you count 10 red colonies and 5 blue colonies (E. coli), then the total
 coliform count is 15, not 10, as E.coli is also part of the total coliform group.


Safe Waste Disposal

Bacterial cultures must be disposed of safely and properly as each colony is made up of
millions of individual bacteria. Contaminated material, such as used Petri dishes, pads and
filter paper, must be disinfected before disposal. This can be accomplished by using a
chlorine solution. Use one of the following options:

1. Add liquid chlorine to each Petri dish until full, allow 10 to 15 minutes contact time with
   the bleach, pour the liquid down the drain, dispose of the test containers in the normal
   waste
2. Or, place the Petri dishes, pads and filter paper into boiling water and heat for at least 30
   minutes (Oxfam-DelAgua WaterTesting Kit-User Manual, nd). You may wish to do this
   outside as the smell may become uncomfortable.
3. Or, place Petri dishes, pads and filter paper open into a bucket which contains at least a
   quarter glass full of bleach (~70 ml) mixed with 2 litres of water. Allow at least 1 hour
   contact time, then dispose of the pads and membranes and boil the Petri dishes to fully
   disinfect and to wash off the bleach.

Always wash your hands thoroughly with soap after handling the contaminated waste and
before touching the disinfected Petri dishes.




                                                                                                91

This document provides an introduction to drinking water quality testing. It discusses the global issues of lack of access to safe drinking water and sanitation. Nearly 900 million people lack access to improved drinking water and over 2.5 billion lack access to improved sanitation. Testing drinking water quality is important to ensure water is safe for drinking and meets World Health Organization guidelines. The document outlines the United Nations Millennium Development Goals related to increasing access to safe drinking water and sanitation.